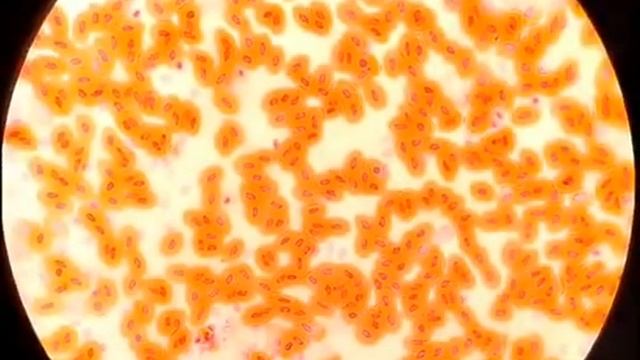
Отличие крови лягушки и человека смотреть онлайн

Автор / Канал: Очковый календарь

EAJ - PNV Programa laburpena-2.mpg

night vision

SmartZoom® ClassRoom: die führende eLearning-Plattform für digitale Mikroskopie in der Medizin

Camera microscopio trinocular

Диета для пресса

Влог доброе воскресенье утро. Шпиц Марк и кошечка Мурочка

Молоко из бочки под микроскопом - Milk under microscope

Extrato 300

ОБЫЧНЫЕ ВЕЩИ НАОБОРОТ? WTFFF!!??
Отличие крови лягушки и человека

119. Наш Яшка), а глазки как у совы.

Сажаю данио на нерест, икра под микроскопом, петушки на нерест.

Megazoom fly / Fliege unter Mikroskop 1600 fach

Форум ЕНА-РООГ-НГО | 12/04/2019, 2 сессия

G8 car led headlight show case

Прямая трансляция пользователя Vladimir Sherbinin

😎Clip On Glasses| Payne Glasses

Слепой на Шкоде

TAOCHIS 2.5 inch Car headlamp bi-xenon projector LED DRL headlight lens chrome shroud with angel ey

Биксеноновые линзы с ангельским глазом

Розв'язування задач на закон Джоуля-Ленца. Фізика. 8 клас.
![[🔥]Meme[🔥] Зелёные очки[🔥] смотреть онлайн [🔥]Meme[🔥] Зелёные очки[🔥] смотреть онлайн](https://pic.rtbcdn.ru/video/2024-10-24/9f/04/9f0409a5a35f1d91eecb77726d5c5374.jpg)
[🔥]Meme[🔥] Зелёные очки[🔥]

как сдлать вертуалный очки реалности с картоном

обзор на мои новые очки
За каждым успешным каналом стоит личность, идея и сотни часов кропотливого труда. Если вы здесь, значит, автор «Очковый календарь» уже сумел зацепить ваше внимание своим уникальным стилем или подачей. А мы на RUVIDEO позаботились о том, чтобы вы могли изучить весь архив его работ в максимально комфортных условиях — без лишней суеты и преград.
Почему за работами канала «Очковый календарь» так интересно наблюдать? Всё просто: это честный контент, который находит отклик в сердцах зрителей. На нашем ресурсе вы можете смотреть онлайн все видео любимого автора бесплатно и в хорошем качестве. Нам важно, чтобы вы видели каждую деталь и слышали каждый нюанс, поэтому мы используем только стабильные плееры из открытых источников Rutube.
Следите за новинками канала, пересматривайте старые шедевры и открывайте для себя новые грани творчества «Очковый календарь». Мы постоянно обновляем ленту, чтобы у вас под рукой всегда были самые свежие выпуски. Никаких сложных регистраций — только вы и творчество, которое вдохновляет. Приятного вам путешествия по миру авторского контента на RUVIDEO!
Видео взято из открытых источников Rutube. Если вы правообладатель, обратитесь к первоисточнику.